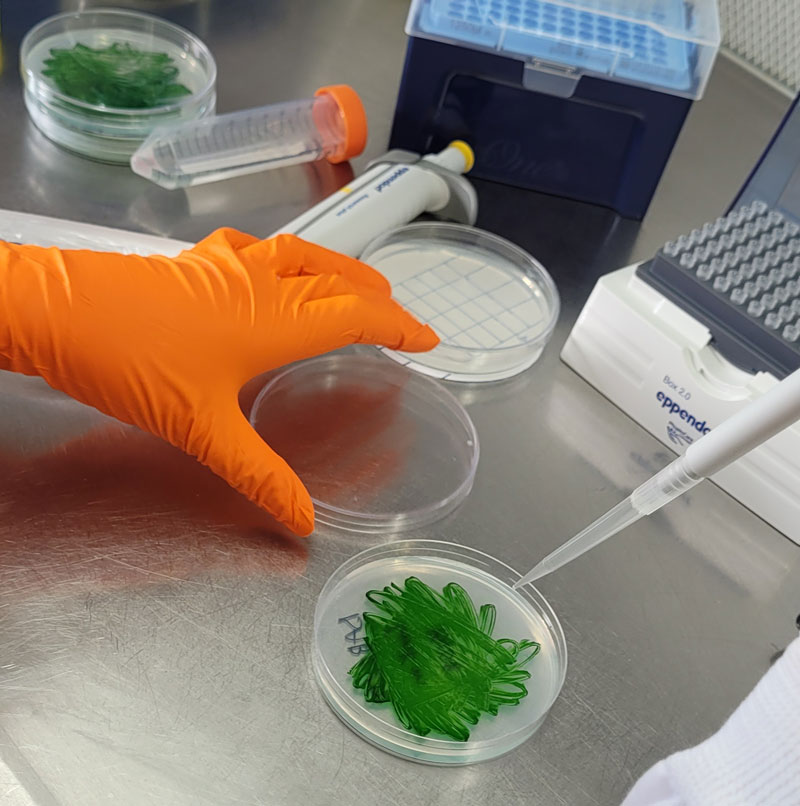

It is difficult to imagine that the body (human or not) can react preventively on a much longer timescale than its own life, such as preparing physiologically for temperature forecasts for future centuries. However, this somewhat describes the behavior of strains of the cyanobacteria species Synechococcus elongatus used in laboratories; single-cell entities that live on light, performing photosynthesis, with a life cycle of approximately one day, according to Brazilian biologist Maria Luísa Jabbur, a researcher at the UK’s John Innes Center, whose article on the topic was published in September in the journal Science. When the bacteria are “warned” of the arriving winter, they quickly prepare themselves—even when the cold arrives several generations later.
Jabbur has studied the biological clock of these cyanobacteria since her undergraduate internship as part of the former Brazilian program Science without Frontiers at Vanderbilt University in the U.S. “Cyanobacteria are an excellent model for circadian rhythms, and for a long time, the focus of research into their biology was geared toward mechanistic and evolutionary aspects, which are much more easily studied in cyanobacteria than in eukaryotes,” she says. “I think that the photoperiodicity issue has been cast aside.” When this gap in studies into the internal clock of cyanobacteria became apparent over a longer time period, during her PhD back at Vanderbilt, she proposed an experiment to her advisor, U.S. biologist Carl Johnson, who in the 1990s was a participant in the identification of three genes (kaiA, kaiB, and kaiC) involved in the circadian clock of these organisms, together with Japanese biologists Takao Kondo and Masahiro Ishiura of Nagoya University and U.S. molecular biologist Susan Golden of the University of California, San Diego.
The proposal seemed absurd, but the researcher did not stifle the student’s creativity, keeping to a reminder on a Post-it note he had on the door of his office: “Progress is made by young scientists who carry out experiments that the old scientists said wouldn’t work.”
“Few reagents were needed; all I had to lose was my own time; I calculated that it would take between one and two weeks, so it was worth it,” recalls Jabbur. It worked the first time and took just a week to obtain a response in two Petri dishes, according to an article published in Quanta, a U.S. scientific journal, in October. Both showed the bacterial colonies as green spots and had been steeped in ice-cold water to simulate the arrival of winter, but one had been maintained in summer conditions, with more hours of light than dark, until it was exposed to the cold. The other contained descendants of a line of bacteria that had been “forewarned” of winter’s arrival by a change in the lighting conditions, which involved more hours of darkness. This latter dish had more abundant green spots—unequivocal signs of survival and reproduction, creating more thrifty colonies. It seemed counterintuitive; after all, these organisms generate their own food from light.
The results led to a more detailed repeat of the experiment, with three groups of cyanobacteria exposed for eight days to different treatments, reflecting the well-defined seasons typically found in temperate zones: eight hours of light and sixteen hours of darkness every day, simulating winter; the same length of time for light and darkness, emulating mid-season; and sixteen hours of light as if it were summer, always at 30 degrees Celsius (°C), the preferred temperature for this bacteria. Under these conditions, the generations of microorganisms succeeded until the researcher collected samples that she placed on ice within small plastic tubes. “From time to time, I took a few drops from the middle of the culture with bacteria in ice and put them on new dishes to see how many cells had survived,” Jabbur recalls. Approximately five days later, the bacteria had reproduced sufficiently to enable counting of the green spots: they were three times more abundant in the group that received winter light, indicating that preceding generations may have adapted to cold conditions, even without being exposed to them. The project, which had been a side interest, became the key focus of her doctoral research, bringing her recognition in the field. “It’s a result that people associate with me.”

Carl Johnson / Vanderbilt UniversityA Post-it on Carl Johnson’s door empowered the student to conduct an unprecedented experimentCarl Johnson / Vanderbilt University
Model clock
According to physicist Gisele Oda, coordinator of the Chronobiology Laboratory of the Institute of Biosciences at the University of São Paulo (IB-USP), the cyanobacteria played a central role in evolving knowledge of chronobiology by debunking, since the 1980s, the deep-seated notion that the biological clock would only be present in organisms with organized cell nuclei, which are absent in these microorganisms. “They demonstrated that all living beings, even unicellular, with and without nuclei, have circadian rhythms,” recounts the researcher, who did not participate in the study but met Jabbur while an undergraduate at IB-USP.
Oda studies how subsurface rodents—tuco-tucos (Ctenomys flamarioni)—distinguish long days from short days even when they spend a large proportion of their time without seeing light (see Pesquisa FAPESP issue n° 261). “The cyanobacteria were even more surprising because they presented seasonality, and on top of that, they can determine that the day is longer in summer than in winter, with each specimen living less than a full day,” she says. “We thought that they would need to live at least 24 hours to conclude that day is longer than night in summer.”
Biologist Carlos Hotta, of the USP Institute of Chemistry (IQ), coordinates a group specializing in the investigation of circadian rhythms in plants and also expressed his surprise at the fact that bacteria have a mechanism to perceive such a long time frame. He did not participate in the study; he defines the cyanobacteria biological clock as completely different from that in other organisms, with a central oscillator that defines the rhythm based on only proteins and their interactions, in addition to having the resources to detect the environment and communicate that information to the organism.
Jabbur explained that this species has approximately 2,700 genes, including the three identified by Johnson and collaborators. Every day, kaiC undergoes a chemical process of gain and loss of phosphorus-containing molecules due to interactions between kaiA and kaiB. This phosphorylation and dephosphorylation movement is synchronized with day and night and occurs through cyclical chemical reactions that depend only on the proteins, without the need for continued activation or transcription of the genes.
Luísa Jabbur / John InnesCyanobacteria cultivated in Petri dishes were exposed to different light conditions to simulate the seasonsLuísa Jabbur / John Innes
From a laboratory standpoint, this protein-based chemical system means that simplified experiments may be conducted using test tubes, without the need for the cells themselves to be present. “That makes this system particularly good for chronobiological studies and allows us to stop the clock for part of the cycle, for example,” says the researcher, who, after her PhD, went to work in the laboratory of British biologist Antony Dodd, who investigates how circadian regulation affects the adaptation of plants and microorganisms to environmental fluctuations.
She found that when exposed to short days, the cyanobacteria change the composition of their membranes, with folds in the phospholipids that make them less rigid, a process known as desaturation. “They do this proactively.” The more permeable membrane enables an increased exchange of molecules between the cells and the tissue, which aids in winter survival.
“For the plants, the capacity of foreseeing the seasons is essential and involves the definition of when to flower or shed leaves,” Hotta compares. Any living being that is not able to tell the time of day and season of the year is at an evolutionary disadvantage. However, to understand that an organism is prepared to deal with something that significantly exceeds its own lifespan, one needs to change the evolutionary standpoint to a view that natural selection acts upon the lineage and not on the individual bacteria, the article states in Science.
This study highlights the notion of photoperiodism as a long-standing phenomenon and provides a model for studying its mechanisms and evolution. Indeed, cyanobacteria understand evolutionary seniority: this type of organism has existed for approximately 3.5 billion years and contributed to creating the possibility of life on earth by producing large quantities of oxygen through photosynthesis.
“We want to use cyanobacteria as a model to understand how photoperiodical responses can evolve in the face of climate change: basically subjecting them to similar conditions as projected for 2100 and seeing how they evolve after some years exposed to those conditions,” proposes Jabbur. Their solutions may, for example, guide the cultivation of food crops in a more productive manner.
Scientific article
JABBUR, M. L. et al. Bacteria can anticipate the seasons: Photoperiodism in cyanobacteria. Science. Vol. 385, no. 6713, pp. 1105–11. Sept. 5, 2024.
